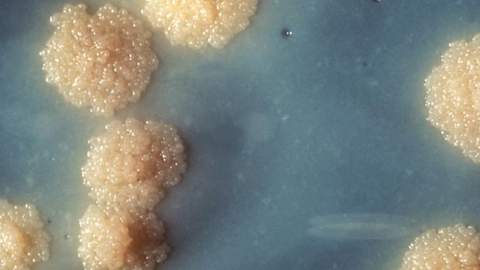

Hoy, 24 de marzo, se celebra el Día Internacional para las Víctimas de Esclavitud y trata de Esclavos. Un día que cada año rinde homenaje a todos los hombres, mujeres y niños que han sido víctimas de esclavitud, producto del racismo y los prejuicios sociales.
La esclavitud es una condición que nace como un fenómeno social, donde el ser humano es tratado sin ningún tipo de respeto. Es obligado a trabajar día y noche en las condiciones más deplorables, sin percibir por ello ningún tipo de remuneración y donde sólo tiene derecho a recibir alimentos y un lugar para dormir en el mejor de los casos. Por lo general, las personas que son usadas como esclavas proceden de lugares del mundo donde hay extrema pobreza, los conocidos como países subdesarrollados.
Se cree que la práctica de la esclavitud tiene su origen en la época de la prehistoria, sin embargo, se institucionalizó a partir de la labranza de las tierras, donde se requería la mano de obra de los esclavos. También fue una manera de castigar a las personas que cometían desacato de las leyes o delitos graves.
El 25 de maro de 2015 se erigió en la sede de las Naciones Unidas de Nueva York, un monumento que rinde homenaje a todas las víctimas de esclavitud en todo el mundo. ‘El Arca del Retorno’ del arquitecto norteamericano de origen haitiano Rodney León, es un recordatorio de los millones de hombres y mujeres que se vulneraron sus derechos humanos y fueron vendidos de manera ilegal para ser tratados como esclavos.

Normas de participación
Esta es la opinión de los lectores, no la de Página66.
Nos reservamos el derecho a eliminar los comentarios inapropiados.
La participación implica que ha leído y acepta las Normas de Participación y Política de Privacidad
Normas de Participación
Política de privacidad
Por seguridad guardamos tu IP
216.73.217.98